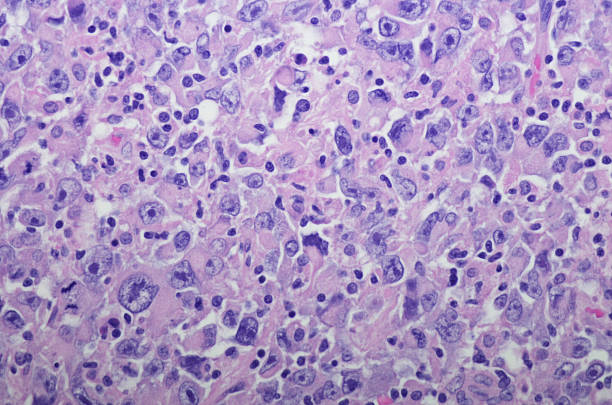

신장암 초기증상 정보를 궁금해 하시는 분들이 많습니다.
이와 관련해서 자세한 내용을 아래에 정리 했습니다.
신장암 초기증상 경우 정확한 정보가 중요합니다.
제대로 알아야 제대로 대응할 수 있기 때문입니다.
아래에는 자세한 정보를 정리 했습니다.



✅신장암 초기증상 초창기에 잡아서 치료하세요
대부분 암의 경우 초기에는 별다른 증상이 없습니다. 그래서 알아 차리기 어렵습니다.
신장암 초기증상 경우도 비슷합니다. 하지만 전문가는 조기에 진단하는 방법을 알고 있습니다.
어떻게 해야 신장암을 조기에 발견할 수 있을까요?
관련된 정보는 아래 전문가 영상을 꼭 시청해보시기 바랍니다!
영상은 클릭하면 재생됩니다.



신장암의 원인과 중요성
신장암은 흡연, 비만, 고혈압 등과 관련된 원인이 있을 수 있습니다. 그러나 암의 발생 원인을 규명하는 것보다 더 중요한 것은 조기 발견입니다. 신장암은 양쪽 신장에서 동시에 발견되는 경우가 드물며 대부분 한쪽에서 발견됩니다.



신장암 초기증상 조기 발견 중요성
신장암이 조기에 발견되면 치료 가능성이 높아집니다. 이러한 조기 진단을 통해 작은 크기의 암이 발견되면 신장을 완전히 제거하지 않고 부분적으로 절제하는 수술이 가능하며, 이는 최근에는 로봇을 이용한 절제술로 더욱 효과적으로 수행됩니다.



신장암 초기증상 진단 방법
신장암은 혈액 검사나 소변 검사로는 조기 진단하기 어렵습니다. 따라서 건강을 유지하고자 하는 목적으로는 초음파 검사를 적어도 일 년에 한 번 받는 것이 좋습니다. 초음파 검사를 통해 작은 크기의 신장암도 조기에 발견할 수 있습니다.



✅신장암 초기증상 3가지
1. 현미경적 혈뇨
현미경적 혈뇨는 신장암의 초기 증상 중 하나로 나타날 수 있습니다. 이는 소변에서 피가 혼합되어 나오는 것을 의미합니다. 때로는 눈에 띄지 않을 수 있지만 검사를 통해 혈뇨가 확인될 수 있습니다. 특히 50세 이상의 연령대에서 현미경적 혈뇨가 나타날 경우, 초음파 검사나 CT 검사와 같은 특수 검사를 받아야 합니다. 이를 통해 신장암의 가능성을 조기에 확인할 수 있습니다.

2. 옆구리 통증
옆구리가 아프거나 통증을 느낄 때는 신장암의 징후일 수 있습니다. 옆구리 통증은 다양한 신장 질환과 관련이 있기 때문에 정확한 원인을 파악하기 위해 정밀 검사가 필요합니다. 또한, 옆구리를 만져보았을 때 어떤 딱딱한 덩어리가 느껴진다면, 이 역시 검사가 필요한 신호일 수 있습니다.



3. 물혹
물혹은 신장에서 발생하는 낭종으로, 별다른 증상이 없을 수 있습니다. 하지만 이러한 낭종이 발견될 경우, 신장암으로 진행할 가능성이 있는 경우도 있습니다. 따라서 물혹이 있는 경우에도 정기적인 검사를 통해 신장의 건강 상태를 모니터링하고, 필요한 경우 추가 검사를 받는 것이 중요합니다.



신장암 초기증상 치료 옵션
신장암은 암이 진행된 경우에 항암 요법이나 방사선 요법에 잘 반응하지 않습니다. 따라서 암이 진행된 경우에는 면역치료나 주사 치료 등의 특수한 치료가 필요합니다. 그러므로 조기 진단이 신장암을 완치하는데 매우 중요합니다.



신장암 초기증상 마무리
신장암은 조기에 발견하고 치료하는 것이 중요한 암 중 하나입니다. 건강을 지키기 위해 정기적으로 초음파 검사를 받고, 만약 어떤 이상 증상이 있다면 반드시 의료 전문가의 도움을 받아야 합니다. 조기 진단을 통해 신장암을 극복할 수 있는 기회를 놓치지 마세요.
